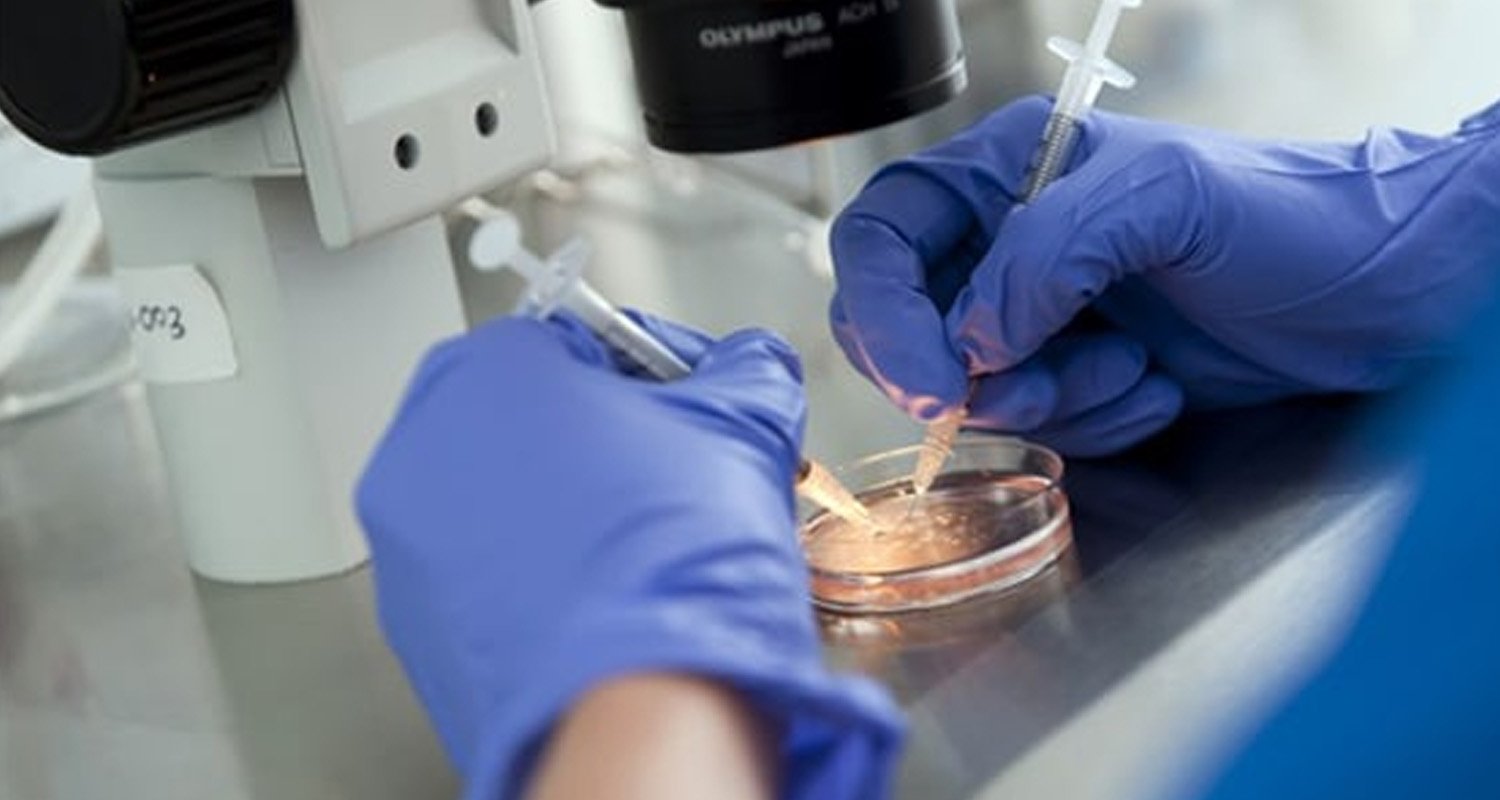

هي أورام رحمية حميدة (غير سرطانية) تصيب الرحم او عنق الرحم وتتكون من ألياف يختلف حجمها ومن الممكن ظهور ورم ليفي واحد او...
ملتزمون بتقديم أفضل رعاية صحية
"صحتكِ و صحة جنينكِ أمانة بين ايدينا . نقدم لكِ رعاية متكاملة طوال رحلة الحمل والولادة."
"اكتشفي عالم الأمومة معنا. نقدم لكِ أحدث التقنيات الطبية والاستشارات المتخصصة في مجال النسائية والتوليد."
"صحتكِ هي أولويتنا. نقدم لكِ تشخيصاً دقيقاً وعلاجاً فعالاً لجميع مشاكل صحتكِ النسائية."
علاج العقم و المساعدة على الإنجاب
رعاية الحوامل
الجراحات النسائية
العقم عند السيدات
العقم عند الرجال
د. رائد فلاح خليــفة
يسعدني ان أرحب بكم في موقعنا الالكتروني الجديد والذي نأمل ان يكون شاملا وغنيا بكافة المعلومات التي ترجونها حول أمراض العقم وأطفال الأنابيب بالاضافة الى موضوعات أخرى مختارة .
أقسم بالله العظيم أن أراقب الله في مهنتي. وأن أصون حياة الإنسان في كافة أدوارها، في كل الظروف والأحوال، باذلًا وسعي في استنقاذها من الموت والمرض والألم والقلق، وأن أحفظ للناس كرامتهم، وأستر عوراتهم، وأكتم سرّهم. وأن أكون على الدوام من وسائل رحمة الله، باذلًا رعايتي الطبية للقريب والبعيد، الصالح والطالح، والصديق والعدو. وأن أثابر على طلب العلم، أسخِّره لنفع الإنسان لا لأذاه. وأن أوقر من علمني، وأعلّم من يصغرني، وأكون أخًا لكل زميل في المهنة الطبية في نطاق البر والتقوى. وأن تكون حياتي مصداق إيماني في سري وعلانيتي، نقيًا مما يشينني أمام الله ورسوله والمؤمنين. والله على ما أقول شهيد.
رعاية طبية متكاملة
ما نوع المشكلة الصحية التي تواجهك ؟
العقم عند السيدات
هي احدى الغدد العديدة الموجودة داخل جسم الانسان والمسؤولة عن افراز هرمونات متعددة تنظم عمل الجسم وأجهزته, تقع الغدة النخامية داخل تجويف عظمي...
نعني بالعقم غير المفسر انه العقم الناتج عن أسباب لم نستطيع أن نجد له تفسيرا بالطرق المتعارف عليها طبيا حتى الان , وتمثل حوالي 15-10% من حالات العقم.
تعتبر قناتي فالوب الانابيب المسؤولة عن انتقال البويضات الناضجة من المبيض الى الرحم حيث يعتبر انسداد هذه القنوات سببا رئيسيا في منع وصول...
عندما يتأخر الحمل عند المرأه تتوجه الى الطبيبه التي قد تطلب منها اجراء بعض الفحوصات للتأكد من سلامتها وسلامة جهازها التناسلي ومن بين...
هناك بعض المخاوف التي تتعرض لها المرأة قبل اجراء عملية اطفال الأنابيب, خوفا من عدم نجاح هذه العملية, لكن شهدت عملية اطفال الانابيب...
التلقيح الصناعي (الاخصاب الصناعي) داخل الجسم هو محاولة اخصاب البويضة داخل جسم المراة عن طريق اخذ السائل المنوي من الزوج وارجاعه الى رحم...
العقم عند الرجال
العقم عند الرجال هو أي حالة تؤثر سلبا على قدرة الحيوانات المنوية عند الرجل على تخصيب البويضة. تتعد الأسباب التي تؤدي الى العقم...
هو الهرمون الذي تطلقه الغدة النخامية الموجودة في جمجمة الانسان والمسؤول عن تنبيه وتحفيز نمو البويضات (المبيض) وانضاجها
احدى الأمراض التي تصيب الخصية عند الرجال نتيجة لحدوث توسع وتمدد غير طبيعي لأوردة الدم داخل كيس الصفن والتي تمتد من.
احدى الأمراض التي تصيب الخصية عند الرجال نتيجة لحدوث توسع وتمدد غير طبيعي لأوردة الدم داخل كيس الصفن والتي تمتد من.
احدى الأمراض التي تصيب الخصية عند الرجال نتيجة لحدوث توسع وتمدد غير طبيعي لأوردة الدم داخل كيس الصفن والتي تمتد من
هو دراسة وتقدير بعض الخصائص للمني وعدد الحيوانات المنوية فيه,للتأكد من حالة العقم لدى الزوج أو للتأكد من نجاح عملية الربط لدى
التلقيح الصناعي
هناك بعض المخاوف التي تتعرض لها المرأة قبل اجراء عملية اطفال الأنابيب, خوفا من عدم نجاح هذه العملية, لكن شهدت عملية اطفال الانابيب...
التلقيح الصناعي (الاخصاب الصناعي) داخل الجسم هو محاولة اخصاب البويضة داخل جسم المراة عن طريق اخذ السائل المنوي من الزوج وارجاعه الى رحم...
يمكن أن نوجز القول على أن تشخيص الأجنة وراثيا بهذه التقنية هو دمج الخبرة في مجال الطب الانجابي الى جانب علم الوراثة الجزئي...
نقل الأجنة هي اخر مرحلة من مراحل عملية الاخصاب الصناعي, وهي من اهم الاجراءات التي يعتمد عليها في نجاح عملية اطفال الانابيب, وهي...
تعرف بمرحلة التطوير قبل زرع الأجنة في رحم الأم, اذ يكون الجنين قد وصل اليوم الخامس بعد عملية الاخصاب بالمختبر, اذ تساعد هذه...
تمر عملية اطفال الانابيب بواسطة الحقن المجهري في المختبر بمراحل مختلفة
مع تطور العلم وتقدم التكنولوجيا أصبح بامكان الزوجين الذين يلجؤون للتلقيح الصناعي اختيار جنس المولود وتعد نسبة نجاح عملية فصل الأجنة باستخدام تقنية...